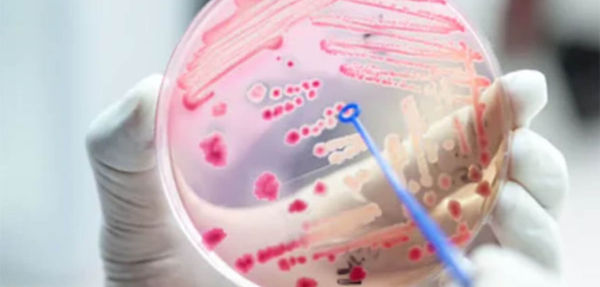
isolation-cultivation-of-specific-bacteria-picture-1_lg.jpg

Isolate Repository Sales
Access a Curated Library of Bacterial Isolates
Advance your research with confidence using verified bacterial strains from the FWRM Labs isolate repository. Our extensive collection provides fully characterized, quality-verified isolates for use in challenge assays, validation studies, and product development.
Each strain in our repository is selected for scientific relevance and reliability, with complete documentation available to support experimental design, reproducibility, and regulatory submission. Whether you need standard reference organisms or specialized isolates, FWRM Labs delivers dependable biological materials ready to meet your research objectives.
Our isolate repository supports:
-
Challenge testing and method validation
-
Antimicrobial and phage efficacy studies
-
Product development and quality assurance
-
Academic and industrial research applications
With every sample, you gain confidence in authenticity, consistency, and performance — ensuring that your work begins with the highest-quality materials.
Why Choose FWRM Labs
Comprehensive Characterization
All isolates are verified through molecular and phenotypic methods, ensuring accurate identification and traceable provenance for every strain.
Quality You Can Trust
Each repository entry undergoes strict quality control to confirm purity, stability, and reproducibility across studies.
Curated for Research Relevance
Our collection includes isolates commonly used in microbiological testing, as well as unique strains relevant to phage research, clinical, and agricultural applications.
Fast, Reliable Access
We offer flexible ordering and delivery options, allowing you to quickly obtain the materials you need without compromising on quality or documentation.
Expert Scientific Support
As a phage-focused CRO, FWRM Labs provides more than samples — we provide insight. Our team is available to guide isolate selection and study design based on your specific goals.